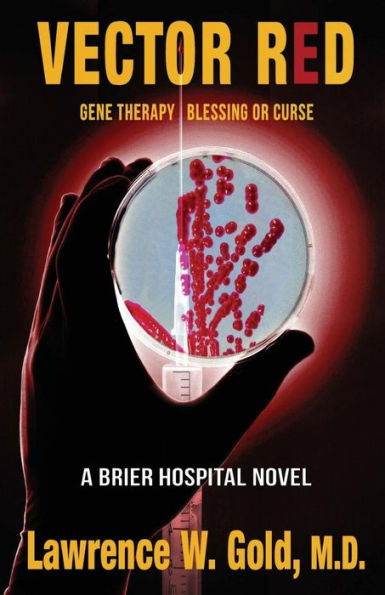
Vector Red: Gene Therapy/ Blessing or Curse

Vector Red: Gene Therapy/ Blessing or Curse
Sara, a young, previously healthy woman, and a missionary, arrives at Brier Hospital with a rash and low-grade fever. In minutes, the rash erupts into destructive skin lesions and Sara goes into shock. Is this an undiagnosed infectious disease, or is Sara the victim of a biological weapon? Is she contagious? Is this the start of an epidemic? In their attempt to fight this disease, physicians call in the CDC. What is it? Who did it? Why did they do it? Can anyone stop it? While Vector Red is medical fiction, the novel introduces the reader to an advanced technique for genetic manipulation with the potential to alter life as we know it, not only today, but for the future. Man may have the ability to change the world, but do we have the intelligence, ethical sensibility, and the foresight to see what's ahead for good or evil.
1134741839
Vector Red: Gene Therapy/ Blessing or Curse
Sara, a young, previously healthy woman, and a missionary, arrives at Brier Hospital with a rash and low-grade fever. In minutes, the rash erupts into destructive skin lesions and Sara goes into shock. Is this an undiagnosed infectious disease, or is Sara the victim of a biological weapon? Is she contagious? Is this the start of an epidemic? In their attempt to fight this disease, physicians call in the CDC. What is it? Who did it? Why did they do it? Can anyone stop it? While Vector Red is medical fiction, the novel introduces the reader to an advanced technique for genetic manipulation with the potential to alter life as we know it, not only today, but for the future. Man may have the ability to change the world, but do we have the intelligence, ethical sensibility, and the foresight to see what's ahead for good or evil.
16.23
In Stock
5
1

Vector Red: Gene Therapy/ Blessing or Curse
472
Vector Red: Gene Therapy/ Blessing or Curse
472Paperback
$16.23
16.23
In Stock

Product Details
| ISBN-13: | 9781540811158 |
|---|---|
| Publisher: | CreateSpace Publishing |
| Publication date: | 12/20/2016 |
| Series: | Brier Hospital , #12 |
| Pages: | 472 |
| Product dimensions: | 5.51(w) x 8.50(h) x 0.95(d) |
From the B&N Reads Blog